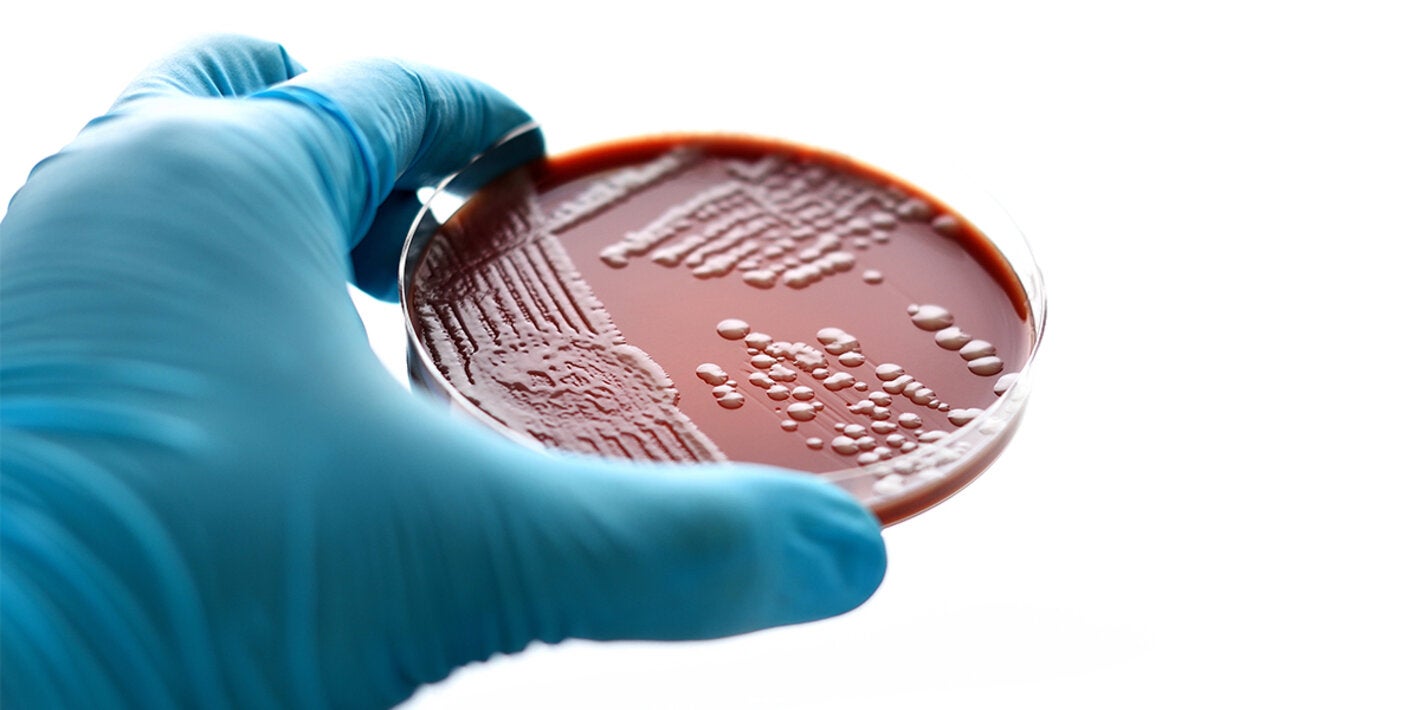
gonorrea

6 de junho de 2019 – A cada dia, há mais de 1 milhão de novos casos de infecções sexualmente transmissíveis (ISTs) curáveis entre pessoas de 15 a 49 anos, conforme dados divulgados nesta quinta-feira (6) pela Organização Mundial da Saúde (OMS). Isso equivale a mais de 376 milhões de novos casos anuais de quatro infecções – clamídia, gonorreia, tricomoníase e sífilis.
“Há uma relativa falta de progresso em parar a propagação de infecções sexualmente transmissíveis no mundo”, disse Peter Salama, diretor executivo para Cobertura Universal de Saúde e Curso de Vida da OMS. “Este é um alerta para um esforço conjunto, a fim de garantir que todos, em todos os lugares, possam acessar os serviços que necessitam para prevenir e tratar essas doenças debilitantes”.
Publicado online pelo Boletim da Organização Mundial da Saúde, a pesquisa mostra que, em homens e mulheres de 15 a 49 anos, houve 127 milhões de novos casos de clamídia em 2016. No mesmo ano, foram 87 milhões de casos de gonorreia, 156 milhões de tricomoníase e 6,3 milhões de sífilis.
Essas ISTs têm um impacto profundo na saúde de adultos e crianças no mundo. Se não forem tratadas, podem levar a efeitos graves e crônicos à saúde, dentre os quais doenças neurológicas e cardiovasculares, infertilidade, gravidez ectópica, natimortos e aumento do risco de HIV. Essas infecções também estão associadas a níveis significativos de estigma e violência doméstica.
Estima-se que a sífilis foi responsável por 200 mil natimortos e óbitos de recém-nascidos em 2016, tornando-se uma das principais causas de perda de bebês no mundo.
Ameaça persistente e endêmica
Desde os últimos dados publicados, de 2012, não houve declínio substancial nas taxas de infecções novas ou existentes. Em média, aproximadamente 1 em cada 25 pessoas no mundo tem pelo menos uma dessas ISTs, conforme os números mais recentes, com algumas tendo múltiplas infecções ao mesmo tempo.
As IST se espalham predominantemente por contato sexual sem proteção, incluindo sexo vaginal, anal e oral. Algumas delas – incluindo clamídia, gonorreia e sífilis – também podem ser transmitidas durante a gravidez e o parto, ou, no caso da sífilis, pelo contato com sangue ou produtos sanguíneos infectados e uso de drogas injetáveis.
As infecções sexualmente transmissíveis são evitáveis por meio de práticas sexuais seguras, como o uso correto e consistente de preservativos e educação sobre saúde sexual.
Testes e tratamentos oportunos e acessíveis são cruciais para reduzir o ônus das ISTs no mundo, juntamente com os esforços para encorajar as pessoas sexualmente ativas a serem testadas para ISTs. A OMS recomenda ainda que as gestantes sejam sistematicamente testadas para sífilis e HIV.
Todas as ISTs bacterianas podem ser tratadas e curadas com medicamentos amplamente disponíveis. No entanto, a escassez recente na oferta global de penicilina benzatina tornou mais difícil o tratamento da sífilis. O aumento rápido da resistência antimicrobiana aos tratamentos de gonorreia também é uma ameaça crescente à saúde e pode fazer com que a doença seja impossível de tratar.
Ampliando o acesso à prevenção, teste e tratamento
A OMS gera estimativas para avaliar a carga global de ISTs e ajudar na resposta de países e instituições parceiras. Isso inclui pesquisas para fortalecer a prevenção, melhorar a qualidade do atendimento, desenvolver diagnósticos point-of-care (de ponta) e novos tratamentos, bem como gerar investimentos no desenvolvimento de vacinas.
Para gerar essas estimativas globais, foram disponibilizados mais dados de mulheres do que de homens. Os dados de prevalência de ISTs em homens ainda são escassos no mundo. A OMS está procurando melhorar a vigilância nacional e global para garantir a disponibilidade de informações confiáveis sobre a extensão do ônus das ISTs.
Os dados, publicados primeiro de forma online no Boletim da OMS, fornecem a base para monitorar o progresso em relação à estratégia do setor de saúde global sobre ISTs, de 2016 a 2021. Essa estratégia, adotada pela Assembleia Mundial da Saúde em maio de 2016, propôs uma rápida expansão das intervenções e serviços baseados em evidências para acabar com as ISTs como uma preocupação de saúde pública até 2030.
Notas aos editores
O documento “Estimativas Globais e Regionais da Prevalência e Incidência de Quatro Infecções Sexualmente Transmissíveis Curáveis em 2016”, foi publicado no Boletim Online da OMS como um pré-lançamento “Online First”. Isso significa que esse artigo ainda não foi formatado e finalizado com correções dos revisores para que o texto final possa ser alterado antes da publicação impressa.
Sobre as quatro ISTs
• A tricomoníase é a mais comum das IST curáveis no mundo. É causada pela infecção por um parasita durante a relação sexual. Clamídia, sífilis e gonorreia são infecções bacterianas.
• Entre os sintomas de uma IST, podem estar lesões genitais, corrimento uretral ou vaginal, dor ao urinar e, nas mulheres, sangramento entre menstruações. No entanto, a maioria dos casos é assintomática. Ou seja, as pessoas podem não estar cientes de que têm uma infecção antes do teste.
• A clamídia e a gonorreia são as principais causas de doença inflamatória pélvica e infertilidade em mulheres. Em seus estágios posteriores, a sífilis pode causar doenças cardiovasculares e neurológicas graves. Todas as quatro doenças estão associadas a um risco aumentado de adquirir e transmitir o HIV.
• A transmissão dessas doenças durante a gravidez pode levar a sérias consequências para os bebês, incluindo morte neonatal, natimortos, baixo peso ao nascer e prematuridade, sepse, cegueira, pneumonia e deformidades congênitas.
Imagem: royaltystockphoto.com/Shutterstock.com



